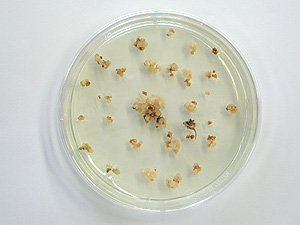
Left: Regular Koshihikari

Honda Discovers Gene Which Improves Regeneration Ability in Rice
August 9, 2005, Japan
Tokyo, August 09, 2005--- Through joint research with Nagoya University, Honda Research Institute Japan Co., Ltd. (HRI-JP), a subsidiary of Honda R&D Co., Ltd., discovered a gene which dramatically improves the regeneration ability of rice. The new discovery will lead the way to more rapid improvements in Koshihikari, the most popular variety of rice in Japan.
Plants have an essential ability to regenerate the whole plant body from a piece of tissue. Plant culture applying this regeneration ability has been utilized for the mass reproduction of commercial seedlings or crop improvements. However, it is known that not all the plant species or varieties can regenerate easily. Many leading varieties of rice in Japan, such as Koshihikari, can rarely be regenerated, resulting in a serious problem of efficient rice improvement. In addition, it has not yet been understood the biological mechanisms regulating the plant regeneration ability.
HRI-JP identified a gene controlling the regeneration ability in rice for the first time in the world by genetic examination of a low regeneration rice variety, Koshihikari. The gene, named "PSR1", produces an enzyme which affects the metabolic pathway of nitrogen, an essential source of nutrition for plants. The research revealed that lower activity of the PSR1 gene in Koshihikari results in low regeneration ability. This finding makes it possible to improve Koshihikari rice with high regeneration ability, and consequently to breed new varieties surpassing Koshihikari easier.
In June 2005, HRI-JP announced the identification of a gene increasing the crop yield of rice. The high yielding Koshihikari, the outcome of this research, will be equipped with the high regeneration ability of the PSR1 gene. Moreover, the gene may be applicable to other crops which are difficult to improve because of its low regeneration ability. The research results will be published online this week through Early Edition (http://www.pnas.org/papbyrecent.shtml) of PNAS (Proceedings of the National Academy of Sciences of the United States of America) in this week and will appear as a printed article on August 16.
Honda has been committed to addressing issues of environmental protection and energy conservation and has been conducting multidimensional efforts leading to the development of technologies for improvement of fuel efficiency. As part of its "Commitment for the Future," Honda is pursuing its R&D efforts in a new area of science technology of this century - genome science -- by building a foundation in the research of rice, which is a model plant for plant genetic research.
Left: Regular Koshihikari

Right: Koshihikari with improved regeneration ability by enhanced PSR1